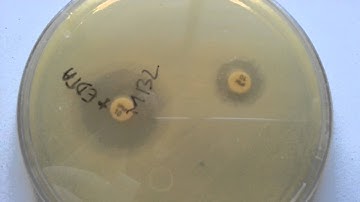
MBL detection/metallo beta lactamase in laboratory

⬇ DOWNLOAD NOW
Kalau muncul iklan pop-up, tutup lalu klik tombol kembali
Download lagu How to Test for MBL-Producing Bacteria 🔬: Genotypic vs. Phenotypic Methods | (MBL Academy Module 4) secara gratis hanya untuk keperluan promosi. Dukung artis favorit kamu dengan membeli musik original di iTunes atau platform resmi lainnya.
 What is MBL Resistance? | Metallo-β-lactamase Explained (Module 1)
What is MBL Resistance? | Metallo-β-lactamase Explained (Module 1)
MBL detection/metallo beta lactamase in laboratory
MBL detection/metallo beta lactamase in laboratory
 The Basics of Lentivirus Production/Packaging: Protocol, Tips, and more!
The Basics of Lentivirus Production/Packaging: Protocol, Tips, and more!
 MBL Tetramers
MBL Tetramers
 See how a lateral flow immunoassay works
See how a lateral flow immunoassay works
 PCM/MM immunophenotype and genetics
PCM/MM immunophenotype and genetics
 Beta-lactamase
Beta-lactamase
 Acid Degradable Lipid Nanoparticles Enhance the Delivery of mRNA
Acid Degradable Lipid Nanoparticles Enhance the Delivery of mRNA